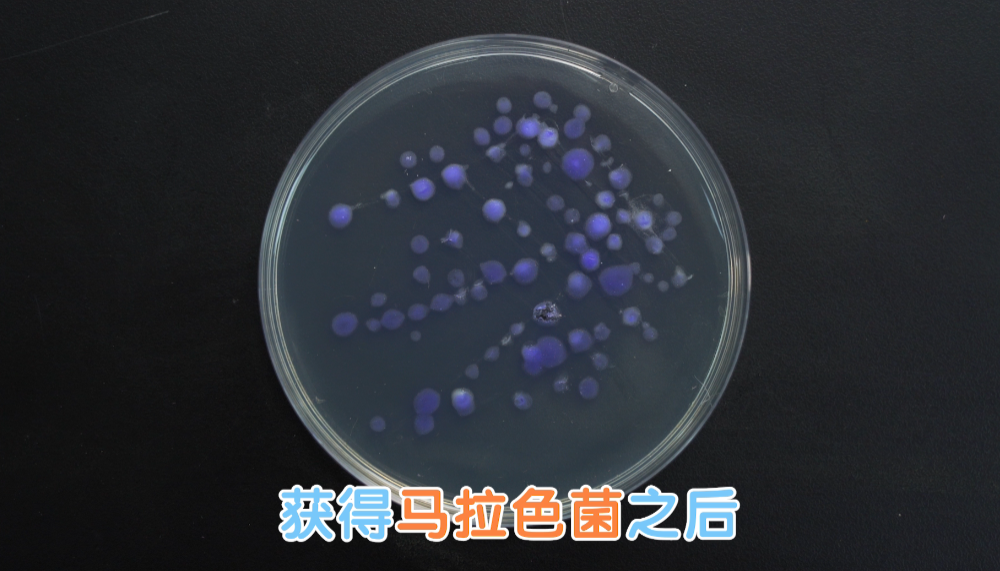

90后英年早秃!?实验告诉你,头发是怎么秃的!
来源:
厦门重森植发 发布时间:2020-12-14 点击:10808
原本以为脱发是中老年才会面临的问题。但随着年轻人生活、工作压力不断增大,脱发也开始了年轻化,甚至连90后也加入秃发大军。

为什么年纪轻轻也会脱发?今天我们来聊聊脱发那些事儿。
我们的头皮,原本是一个相对稳定的小生态系统。其中,有两大主角分别是油脂和真菌。

正常情况下,头皮会分泌适量的油脂,而马拉色菌靠吞噬油脂,然后排出脂肪酸。

它排出的脂肪酸,会破坏头皮屏障,引起角质细胞的脱落。这就是我们经常所说的头皮屑。
头屑,一般来说是我们人体的生理代谢。但当经常熬夜、作息不规律、吃的又特别辛辣导致内分泌失调,就会分泌过多的油脂。

头皮溢出的油脂堵住了毛囊,也为“嗜脂成性”的马拉色菌提供了大量的食物。

从而马拉色菌大量繁殖,头皮的生态平衡被破坏,引起头皮角质层异常、皮肤屏障功能破坏,直接感受就是头屑特别多,头皮特别容易痒,这就是真菌引起的脂溢性皮炎。特别严重的甚至会影响头发的生长,导致脱发。
脂溢性皮炎的病人中,年轻人居多。一旦到了夏天,加上熬夜就会使脂溢性皮炎加重。有些病人因为平时没什么症状,可能只是偶尔脸上会红一下,并没有其他的不舒服,所以就不太注意。
简单!常见的解决方案是使用酮康唑或二硫化硒的洗剂。

两者的效果到底如何,我们特地找来了,两个同样受脂溢性皮炎困扰的小伙伴,做了一次实测试:
测试前,首先对两名实验员的头皮状况进行检测,通过专业的毛囊检测仪放大五百倍后观察可以看见,两人的头皮状况差不多,都是头屑多、头皮油腻、毛囊堵塞的现象严重。


然后将两位实验员安排在同一家酒店里,进行了为期7天的实验。实验中,我们严格控制变量,保证两人作息相同,饮食相同,洗头发的频率相同,同时,将酮康唑和二硫化硒粉末,分别配置成浓度为2%的溶液,用相同的量分别在两人头皮上进行涂抹给药。

一般来说,酮康唑本身是白色的,与空气接触后会发生氧化成粉色,不影响使用。
分别在3天后、7天后,检测人员上门进行毛囊检测。7天结果显示,两位实验员的头皮状况,都有肉眼可见的明显改善。
通过专业毛囊检测仪检测显示,使用二硫化硒的实验员,还有少许毛囊堵塞和头屑现象;使用酮康唑的实验员,头皮清爽不油腻,未发现毛囊堵塞现象,效果出色。
对抗脂溢性皮炎,最重要的就是抑菌,也就是抑制马拉色菌的增殖和生长。我们在专业的实验室做了一个更直观的实验。
第一步,我们在脂溢性皮炎患者的皮损区刮片取样,接种于培养基中。

培养基中含有马拉色菌的染色剂,在32℃的温度下培养7天,获得马拉色菌。培养皿中显示紫色的就是马拉色菌。

第二步,将纯度为98%的酮康唑和97%的二硫化硒粉末,分别加入不同的培养基中,使获得的两种含药培养基药物浓度都为2%。

第三步,挑取马拉色菌,接种于含有药物的培养基中。另外,将一个不使用药物的培养基作为空白对照。

24小时培养结果显示,未使用药液的对照组马拉色菌菌落密集。相比之下,使用酮康唑和二硫化硒之后,菌落数量和大小都有显著下降。这说明两者对马拉色菌的增殖和生长都有着显著的抑制效果。其中,使用二硫化硒之后,菌落总数为37CFU;而使用酮康唑之后,菌落总数为9CFU。

第四步,进一步用显微镜观察显示,使用酮康唑和二硫化硒之后,马拉色菌均出现细胞结构坏死现象,但使用酮康唑的马拉色菌群数量明显减少,而二硫化硒还存在少量菌群存活。

通过这两个实验,可以观察到,酮康唑和二硫化硒在控油和抑制马拉色菌方面,都有比较明显的效果。其中酮康唑的效果都更突出。
首先,减少通宵熬夜,规律的作息和健康的饮食,可以调节内分泌,减少头皮油脂的过多分泌。
其次,可以使用外洗的药物,比如二硫化硒和酮康唑,对局部的真菌繁殖有一定的抑制作用。搭配洗发水使用,防脱又健康。
最后,需要注意的是,脂溢性皮炎的治疗是一个综合治疗。不是单纯用一个药物就能彻底解决,脂溢性皮炎的病程通常比较长,而且很容易反复发作,所以它的治疗是一个长期的过程。
90后英年早秃!?实验告诉你,头发是怎么秃的!
来源:
毛大夫植发 发布时间:2020-12-14 点击:10808
原本以为脱发是中老年才会面临的问题。但随着年轻人生活、工作压力不断增大,脱发也开始了年轻化,甚至连90后也加入秃发大军。

为什么年纪轻轻也会脱发?今天我们来聊聊脱发那些事儿。
我们的头皮,原本是一个相对稳定的小生态系统。其中,有两大主角分别是油脂和真菌。

正常情况下,头皮会分泌适量的油脂,而马拉色菌靠吞噬油脂,然后排出脂肪酸。

它排出的脂肪酸,会破坏头皮屏障,引起角质细胞的脱落。这就是我们经常所说的头皮屑。
头屑,一般来说是我们人体的生理代谢。但当经常熬夜、作息不规律、吃的又特别辛辣导致内分泌失调,就会分泌过多的油脂。

头皮溢出的油脂堵住了毛囊,也为“嗜脂成性”的马拉色菌提供了大量的食物。

从而马拉色菌大量繁殖,头皮的生态平衡被破坏,引起头皮角质层异常、皮肤屏障功能破坏,直接感受就是头屑特别多,头皮特别容易痒,这就是真菌引起的脂溢性皮炎。特别严重的甚至会影响头发的生长,导致脱发。
脂溢性皮炎的病人中,年轻人居多。一旦到了夏天,加上熬夜就会使脂溢性皮炎加重。有些病人因为平时没什么症状,可能只是偶尔脸上会红一下,并没有其他的不舒服,所以就不太注意。
简单!常见的解决方案是使用酮康唑或二硫化硒的洗剂。

两者的效果到底如何,我们特地找来了,两个同样受脂溢性皮炎困扰的小伙伴,做了一次实测试:
测试前,首先对两名实验员的头皮状况进行检测,通过专业的毛囊检测仪放大五百倍后观察可以看见,两人的头皮状况差不多,都是头屑多、头皮油腻、毛囊堵塞的现象严重。


然后将两位实验员安排在同一家酒店里,进行了为期7天的实验。实验中,我们严格控制变量,保证两人作息相同,饮食相同,洗头发的频率相同,同时,将酮康唑和二硫化硒粉末,分别配置成浓度为2%的溶液,用相同的量分别在两人头皮上进行涂抹给药。

一般来说,酮康唑本身是白色的,与空气接触后会发生氧化成粉色,不影响使用。
分别在3天后、7天后,检测人员上门进行毛囊检测。7天结果显示,两位实验员的头皮状况,都有肉眼可见的明显改善。
通过专业毛囊检测仪检测显示,使用二硫化硒的实验员,还有少许毛囊堵塞和头屑现象;使用酮康唑的实验员,头皮清爽不油腻,未发现毛囊堵塞现象,效果出色。
对抗脂溢性皮炎,最重要的就是抑菌,也就是抑制马拉色菌的增殖和生长。我们在专业的实验室做了一个更直观的实验。
第一步,我们在脂溢性皮炎患者的皮损区刮片取样,接种于培养基中。

培养基中含有马拉色菌的染色剂,在32℃的温度下培养7天,获得马拉色菌。培养皿中显示紫色的就是马拉色菌。
第二步,将纯度为98%的酮康唑和97%的二硫化硒粉末,分别加入不同的培养基中,使获得的两种含药培养基药物浓度都为2%。

第三步,挑取马拉色菌,接种于含有药物的培养基中。另外,将一个不使用药物的培养基作为空白对照。

24小时培养结果显示,未使用药液的对照组马拉色菌菌落密集。相比之下,使用酮康唑和二硫化硒之后,菌落数量和大小都有显著下降。这说明两者对马拉色菌的增殖和生长都有着显著的抑制效果。其中,使用二硫化硒之后,菌落总数为37CFU;而使用酮康唑之后,菌落总数为9CFU。

第四步,进一步用显微镜观察显示,使用酮康唑和二硫化硒之后,马拉色菌均出现细胞结构坏死现象,但使用酮康唑的马拉色菌群数量明显减少,而二硫化硒还存在少量菌群存活。

通过这两个实验,可以观察到,酮康唑和二硫化硒在控油和抑制马拉色菌方面,都有比较明显的效果。其中酮康唑的效果都更突出。
首先,减少通宵熬夜,规律的作息和健康的饮食,可以调节内分泌,减少头皮油脂的过多分泌。
其次,可以使用外洗的药物,比如二硫化硒和酮康唑,对局部的真菌繁殖有一定的抑制作用。搭配洗发水使用,防脱又健康。
最后,需要注意的是,脂溢性皮炎的治疗是一个综合治疗。不是单纯用一个药物就能彻底解决,脂溢性皮炎的病程通常比较长,而且很容易反复发作,所以它的治疗是一个长期的过程。
-
90后英年早秃!?实验告诉你,头发是怎么秃的!
擅长项目
